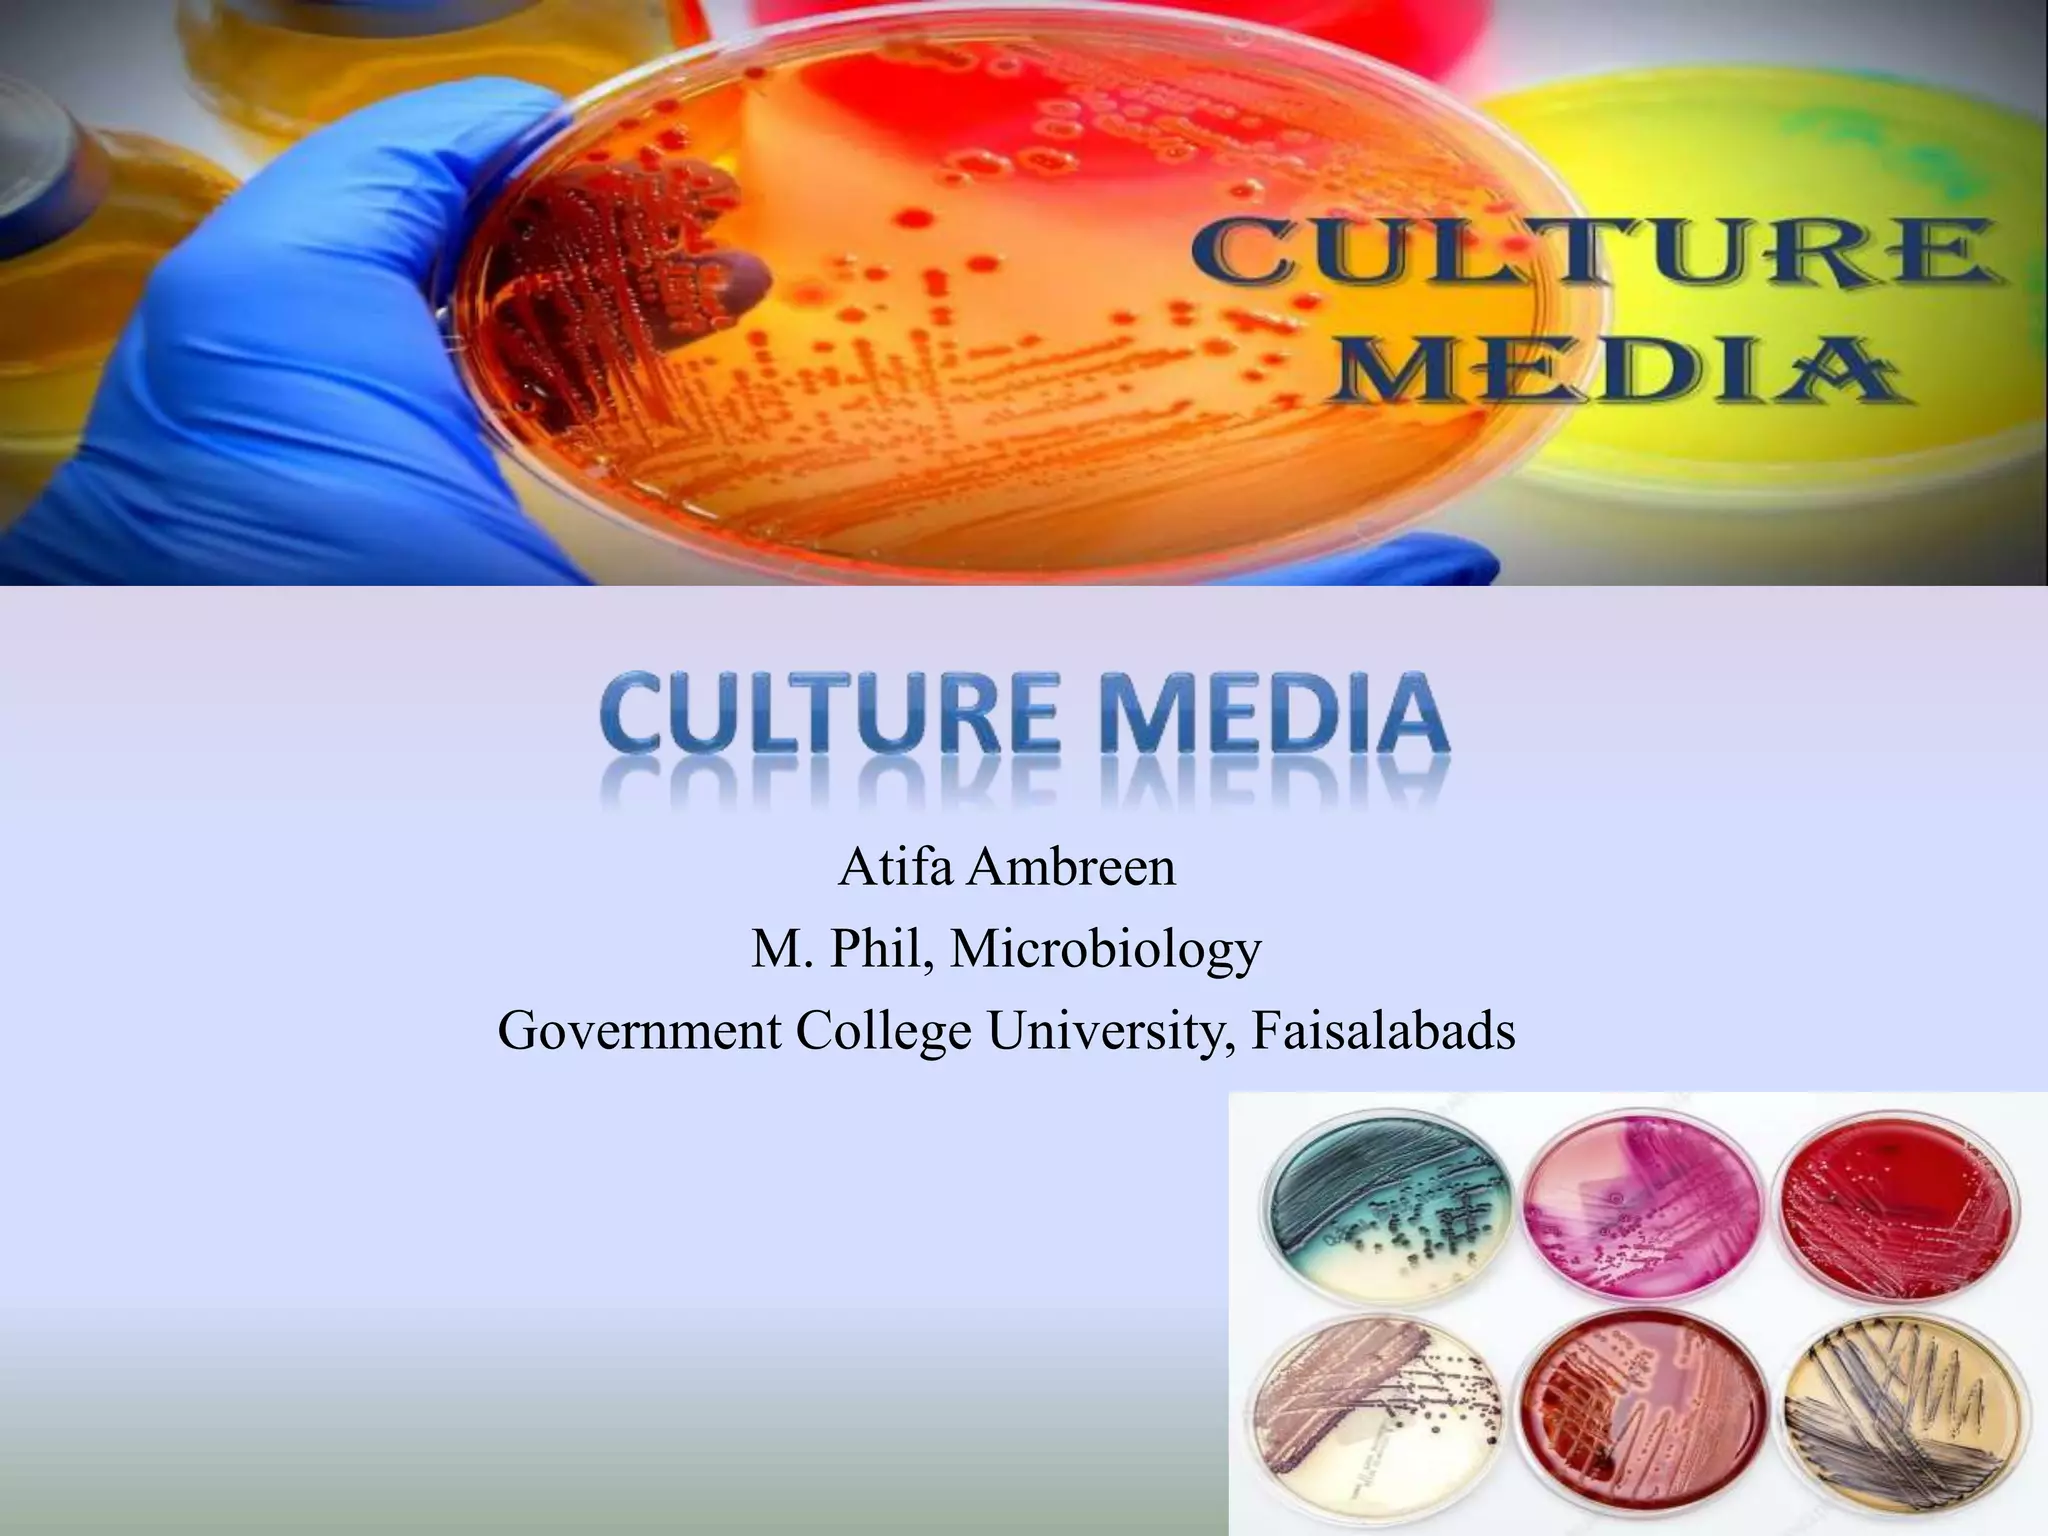

The Food That Build The Body Is Called All food groups carbohydrates proteins fats vitamins and minerals work together to give your body energy and nutrients They help build and maintain body cells and tissues Your body is made up of approximately 100 trillion
Substances added to a food to produce a desired effect used to keep a food safe for a longer period of time to improve good source of Study with Quizlet and memorize flashcards Body building food refers to the food that helps in building muscles development growth provide energy and builds tissues as well They reduce body fat as well These foods
The Food That Build The Body Is Called

The Food That Build The Body Is Called
http://media-cache-ak0.pinimg.com/736x/97/72/5a/97725afcc43aa13836bba0cf6c8d2b73.jpg

Our Products Arab Otsuka
https://arabotsuka.com/wp-content/uploads/2024/06/all-new.png

X By Wingixx On Newgrounds
https://art.ngfiles.com/images/3160000/3160239_wingixx_x.png?f1681782576
Food products that have been grown without the use of any chemical pesticides herbicides or fertilizers What do nutrients provide the body with What are the three types of Proteins can be described as the building blocks that help the body to grow Proteins are the only nutrients that contain nitrogen in addition to carbon hydrogen and oxygen The proteins that
There are more than 40 different nutrients in foods These six are called essential fats carbs protein vitamins minerals and water for your body Protein helps you Build strong There are seven essential components or substances called nutrients in our food They are i Carbohydrates ii Fats iii Proteins iv Mineral salts v Vitamins vi Water vii Fibre also called roughage
More picture related to The Food That Build The Body Is Called
ALCPT Elementary Lesson 5 Vocabulary List Baamboozle Baamboozle
https://media.baamboozle.com/uploads/images/32436/1609444975_121145

Spring Came Northern Siberia Winds Sims 4 Mods Clothes The Sims 4
https://i.pinimg.com/736x/c6/7b/61/c67b611fddc0909843a1c9636a183af6.jpg

Top Gym Tips On Instagram MUSCLE BUILDING FOOD LIST By
https://i.pinimg.com/originals/70/a5/57/70a5570ec961d728cf43cbd6d4fa1593.jpg
The food we eat our diet is made up of different biological molecules which give us energy and contain chemicals we need to grow and repair and help cells function in our body Different For instance the body breaks down dietary proteins into individual amino acids and uses them to build new proteins Similarly it metabolizes carbohydrates from food to release
There are six classes of nutrients required for the body to function and maintain overall health These are carbohydrates lipids proteins water vitamins and minerals Any substance in food that the body needs is called a nutrient There are six major types of nutrients carbohydrates proteins lipids water minerals and vitamins Carbohydrates

Culture Media PPT
https://image.slidesharecdn.com/culturemedia-210308163306/75/Culture-media-1-2048.jpg

Food Web Definition Trophic Levels Types And Example
https://www.sciencefacts.net/wp-content/uploads/2023/01/Food-Web.jpg

https://www.livestrong.com › article
All food groups carbohydrates proteins fats vitamins and minerals work together to give your body energy and nutrients They help build and maintain body cells and tissues Your body is made up of approximately 100 trillion

https://quizlet.com
Substances added to a food to produce a desired effect used to keep a food safe for a longer period of time to improve good source of Study with Quizlet and memorize flashcards

Spooky Season Trivia Game Jeopardy Template
Culture Media PPT

Electrical Burn

9 Heart Pains Leta Herman Author Speaker Publisher

Excretory System In Human Beings PPT

Tion MUSCLE BUILDING SHOPPING LIST TAG A FRIEND WHO NEEDS TO SEE THIS

Tion MUSCLE BUILDING SHOPPING LIST TAG A FRIEND WHO NEEDS TO SEE THIS

300 Teamwork Pictures Wallpapers

Exploring Medieval Times A Journey Through History

Nutrition In Plants PPT
The Food That Build The Body Is Called - Proteins can be described as the building blocks that help the body to grow Proteins are the only nutrients that contain nitrogen in addition to carbon hydrogen and oxygen The proteins that
